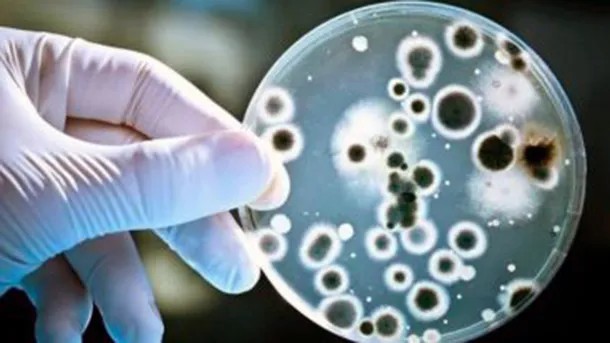

Qué es el Streptococcus Pyogenes, bacteria que ya causó la muerte de 16 personas
Desde finales del año pasado hay alerta por esta bacteria en varios países de Europa y ahora ha llegado a la Argentina, causando 118 casos confirmados y 16 muertes entre ellos.
El 19 de diciembre siguiente, fue la Organización Panamericana de la Salud (OPS) la que también emitió un comunicado debido a un aumento de casos registrado en Uruguay, poniendo en alerta al mundo sobre el avance de esta bacteria Gram-positiva que es la causa bacteriana más frecuente de faringitis aguda e infecciones cutáneas como impétigo, celulitis y escarlatina.
Qué es y cómo se contagia el Streptococcus pyogenes
El Streptococcus pyogenes, también conocido como Streptococcus grupo A, en general causa enfermedades leves como amigdalitis, faringitis, impétigo, celulitis y escarlatina. Pero en raras ocasiones la infección puede conducir a la enfermedad invasiva que puede provocar condiciones potencialmente mortales, siendo responsable de más de 500.000 muertes anuales en todo el mundo.
La transmisión ocurre por contacto cercano con una persona infectada y puede transmitirse a través de la tos, los estornudos o el contacto con una herida.
El período de incubación para la enfermedad varía de acuerdo a la presentación clínica, entre 1 a 3 días. El tratamiento de las personas infectadas con antibiótico durante por lo menos 24 horas elimina por lo general su capacidad de propagación.
Qué enfermedades causa el Streptococcus pyogenes
La faringitis se diagnostica mediante cultivos bacterianos y se trata con antibióticos. La higiene de las manos y la higiene personal pueden ayudar a controlar la transmisión.
Los síntomas de la faringitis son dolor de garganta; fiebre; cefaleas; dolor abdominal; náuseas y vómitos; enrojecimiento de faringe y amígdalas; mal aliento; ganglios aumentados de tamaño en el cuello.
En lo referido a la escarlatina los síntomas más frecuentes son garganta roja y adolorida; fiebre (38.3 °C o más); erupción color rojo con textura de papel de lija; piel de color rojo intenso en los pliegues de axila, codo e ingle; recubrimiento blancuzco sobre la lengua o el fondo de la garganta; lengua «aframbuesada»; dolor de cabeza; náuseas o vómitos; inflamación de los ganglios; dolores en el cuerpo.
Qué hacer y qué no hacer ante el Streptococcus pyogenes
Ante la presencia de algunos de estos síntomas es importante evitar la automedicación con antibióticos y realizar una consulta médica para tener diagnóstico oportuno.
En el caso de recibir indicación médica de tratamiento antibiótico, es fundamental completar el esquema (no acortar ni abandonar los tratamientos anticipadamente), ya que la utilización inadecuada de los antibióticos promueve la resistencia bacteriana, hecho que atenta contra su efectividad en el futuro.
Las personas enfermas deben evitar concurrir a lugares públicos (trabajo, escuela) y restringir los contactos hogareños. Además es de importancia lavarse las manos frecuentemente; no compartir objetos de uso personal (cubiertos, vasos, toallas, entre otros) y ventilar adecuadamente y de forma regular los ambientes.

